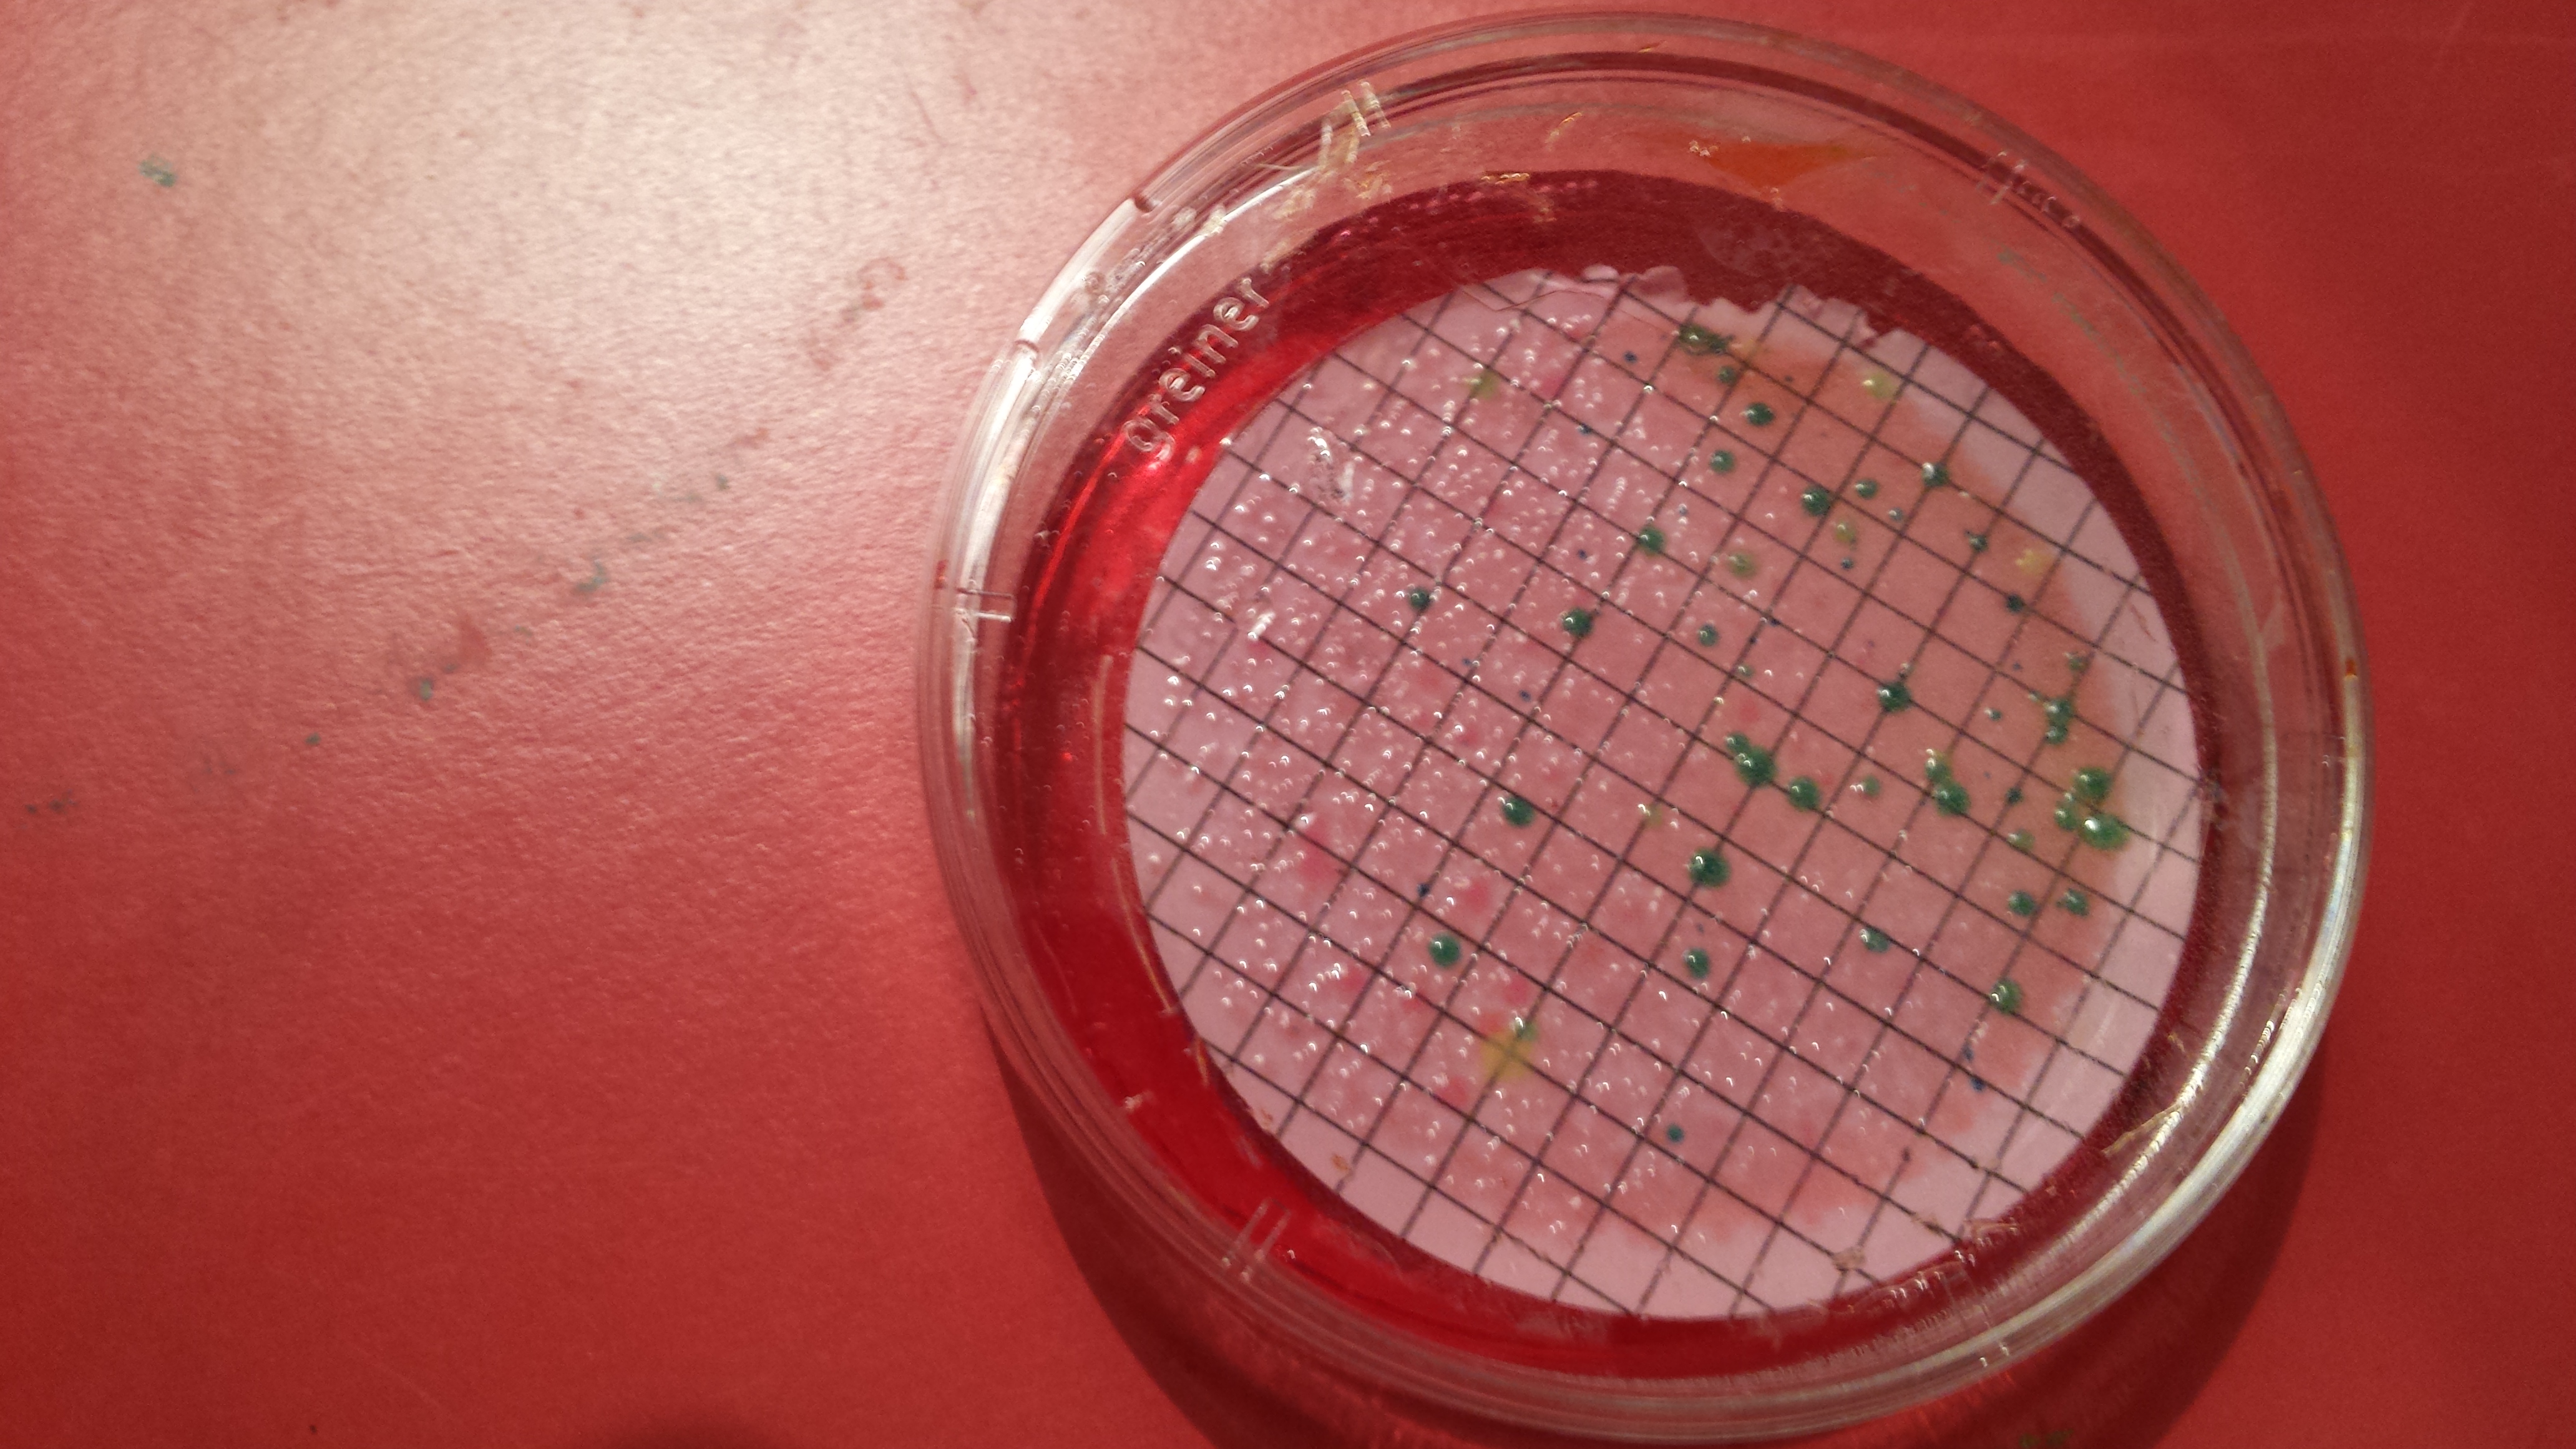

Autumn 2016
Day 6
River site day is always my favourite! Three rivers and a pub coffee. Until the phone rang and we had to deal with the cottage landlady who was not pleased with us “doing science experiments”. Her attempts to kick us out on the final night were matched with defiance..where else were we supposed to go?! Sad ending to what was a great field season in Norfolk. Still, there’s always more work to be done!
Bonus: The river Wensum….so gorgeous..and that tunnel under the pub really does look like a slippery slide..one day I will have to try it.
Not impressed with: Rude people..
Day 5
Today was one for the #fieldworkfails. Tara sprained her wrist just before we were about to leave for sampling. Ouch! We were due out on the broads with Geoff Phillips who luckily agreed to be a replacement sampling partner. We needed to get both mine and Tara’s samples, as well as ekman grabs for Paulo’s statoblast work, so Geoff’s help was much appreciated! Got a lucky dip grab of zebra muscles at Wroxham. Thick black mud proved easier to decant with hands into sampling bags than the standard shake and pour method. The ice-cream boat was still in business despite the weather.
Bonus: Even though the boat was full of mud I did not fall over..just slipped..many times.
Not impressed with: Ekman grabs…seriously..people have built space rockets, are these really the go to equipment for collecting sediment other than corers?!
Day 4
Today was a two site day. Tara and I convinced ourselves that after both submitting our PhDs pre-fieldwork we deserved a fancy lunch, considering we saved 2 house by sampling just two sites. Sampled windy Ormesby and the lush Burntfen on an unimaginable estate owned by a lady wearing a fancy dressing gown and a lama farm.
Bonus: Washing my hair and eating cake.
Not impressed with: Peter’s escapee millipedes following me around the house.
Day 3
Met up with Andrea Kelly from the Broads Authority to access Crome’s Broad. A walk through the marshes, alongside fens and dykes meant we got to see some rare aquatic macrophytes. BUT whilst mooring the boat I nearly ended up underneath the boardwalk due to well disguised, sinky mud holes. I got out with shoes intact though, score! Walked around all day with squelchy mud feet, but no leeches. Peter’s collection of random animal crap which he is using to search for beetles is proving fruitful, although not sure about the smell..
Bonus: The smell of the incubators in my cottage lab is becoming surprisingly pleasant (smell=data generation).
Not impressed with: holes that cover themselves with grass…
Day 2
Headed out to three National Trust sites in The Broads which are now filled with overwintering water fowl (More E.coli?). Spotted a few plants still in flower..yes, this makes me happy. Just in case you wanted to know it was Lamium album, Epilobium hirsutum, Mentha aquatica and Eupatorium cannabinum. Used derelict, leech filled boats as water filtering platforms -it’s better than sinking in the mud! Unfortunately I broke Paulo’s specially made mud collecting ladle on a plastic pole. Oops.
Bonus: Saw an adder. Swans didn’t attack us and the sun was shining, for a while at least. Oh, and no more melted agar plates!
Not impressed with: Roads that think they are rivers.. (see picture below).
Day 1
Woah. Fieldwork reality check day. The day things go wrong.
Pulled my back..still need to carry litres of water every day till Sunday. Open fridge to find my contingency agar plates melted..WHAT?! Still filtering water from the charming Blicking lake..it’s going to be a long night. However, signs of autumn are here and not just Tara dressed in a makeshift onesie (how do you even spell that?!), more the abundance of mushrooms and red tinged tree leaves.
Bonus: Didn’t fall over today. It didn’t rain and it’s great being back outside again after recent long office hours. Oh and have yet to crunch/maul the hire van!BOOM!
Not impressed with: The Travelodge receptionist at the M6 southbound service station who couldn’t quite believe I was driving a van…
Summer 2016
Day 6
River day: Waveney, Wensum and Bure! Today was the last sampling trip for this season and we sampled river sites, which on a sunny day were bound to be bank full with people. Felt like we were on ‘I’m a gold panner get me out of here!’, with the sieve and bucket for filtering protists and cryptosporidum- Tara’s project. Decided that the best way to cool off was by sitting in the middle of the river only to start sinking in the mud and having to casually haul myself out….
Realisations: Horseflies are bastards.
Day 5
Stunning day in the Broads. Hopped on the boat with Geoff Phillips and headed to 3 sites. Clouds overhead, ice-cream boat alongside (sadly no cash on us). I love these days (not the having no cash to buy ice-cream bit though), when you get that sightly overwhelming feeling that your job is bloody awesome ( disclaimer: finished my work at 8pm – clearly euphoric).
Realisations: I want a boat..mainly to look at plants from and drink wine on.
Day 4
I can’t remember ever sweating this much in my life! (and I went to the gym once…ahem.). Today reminded us how much a site can change from one month to the next, meaning chest waders were defunct and sinking mud the primary barrier to accessing the sites. Challenging day but still got those water samples.
Realisations: Perfume eau de anoxic-muddette and outfit pictured below will not make London fashion week. Mosquitoes are bastards.
Day 3
Two site day which meant time for catching up on the mess left after last nights craziness. The look you get when you ask two teenagers if you can walk past their tent to get a water sample…some mother’s children!! Gorgeous site accessible by boat. My steering needs practice..
Realisations: Finishing at 9.30pm is BLISS. Carl Sayer is the Norfolk Pond Guru (as referred to by the locals).
Day 2
SO hot in the Broads. Longingly staring at people on holiday in their boats along the river… Three sites done. The best feeling after a hot sweaty long day in the field is a can of ice cold lemonade, hanging your head out the car window like a dog and an ice cold shower.
Realisations: 1am finishes are tiring..I am getting old. Also, Google Maps is still a bastard.

Day 1
I had forgotten how nice Norfolk was. Three sites done. Out with the HydroScape Natural History Museum team: Beth, Tara, Paulo and Peter. Collecting data on bryozoans (SO beautiful), disease agents and of course E.coli. Getting the hang of my makeshift lab. Feels like home already.
Realisations: How long it actually takes to find and drive to sites…Google maps you are a bastard sometimes.
Arrival
Arrived at the beautiful Aylesham cottage today and immediately crunched the van wing mirror, followed by a luxuriously large scratch down the side for good measure. Moving on swiftly…the make shift lab is looking good. Ready for our first sampling session on Sunday morning. So excited!
Norfolk Broads fieldwork
First fieldwork season starts on the 16th of July 2016. Currently prepping hundreds of E.coli loving media plates, organizing equipment and logistics.